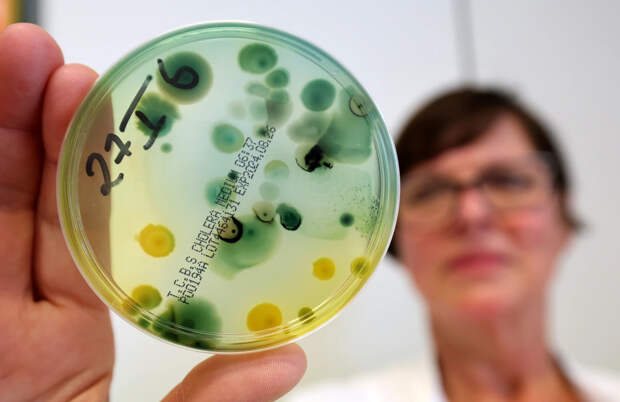

На турецких курортах фиксируют случаи заражения опасной бактерией Vibrio. Люди жалуются на сильную рвоту, высокую температуру и обезвоживание. Кто в зоне особого риска и как защититься, рассказал врач-иммунолог Владислав Жемчугов.
Турция, ежегодно привлекающая миллионы туристов из России, в этом сезоне неожиданно преподнесла отдыхающим неприятный сюрприз.
Десятки из них оказались в больницах после купания в море. Причиной стало заражение бактерией Vibrio. Она активизируется в жаркую погоду, быстро размножается в солёной воде и может попадать в организм через моллюсков. Первые признаки заражения - резкая слабость, тошнота, высокая температура и обезвоживание.По словам врача-иммунолога Владислава Жемчугова, у этой бактерии есть "родственники", знакомые человечеству уже давно.
Ну, вибрионы - это такие подвижные микробы с хвостиком. Самые известные из них - это вибриохолера, это холерный вибрион, который вызывает холеру. Он живёт в пресной воде, богатой белком,
- объяснил специалист в эксклюзивном интервью Царьграду.
Но если холера развивается в стоячих пресных водоёмах, то в Турции ситуация иная.
Есть Vibrio, которые живут в морской воде. Они любят солёную воду и размножаются, когда очень жаркая погода и вода сильно прогревается,
- отметил эксперт.
Именно в августе и начале сентября отмечается максимальный риск. В это время море прогревается до рекордных температур, и бактерии чувствуют себя особенно комфортно. По словам врача, вспышки фиксировались даже в странах, где никто этого не ожидал:
Даже был случай, что лето было жаркое, и эти Vibrio размножались в Балтийском море, там, где очень мелко и обычно холодно.
Они вызывают желудочно-кишечные симптомы: понос, рвота и высокая температура.Стоит ли теперь совсем отказаться от поездок в Турцию? Врач убеждён, что паниковать не стоит, но меры предосторожности необходимы. Главный совет - внимательнее относиться к питанию и напиткам:
Надо пить только проверенную воду из запечатанных бутылок. На улице не пить, не есть. В жару надо стараться не брать те продукты, которые содержат белковый крем, сырое мясо, паштеты. Салаты, которые долго могут стоять на витрине. Это наиболее опасная вещь - со сметаной, с майонезом,
- подчеркнул специалист.
Отдельное внимание стоит уделить детям. Их организм в большей степени уязвим к обезвоживанию, поэтому при появлении первых признаков заражения стоит немедленно обратиться к врачу и задействовать страховку.
Также эксперт рекомендует заранее уточнять обстановку через официальные каналы:
Надо обратиться в наш Роспотребнадзор. На сайте будет написано, где наиболее опасные места. Ну, и свои турагентства трясти, чтобы они разузнали у турецкого санэпиднадзора, где и как обстановка.
В итоге вывод один: море и солнце приносят радость, но в жаркое время даже они могут быть источником серьёзной опасности. Поэтому туристам стоит соблюдать осторожность.
Напомним, ранее об угрозе для отдыхающих на популярных турецких курортах предупредили турецкие медики. Подробнее об этом писало издание kp.ru.
Свежие комментарии